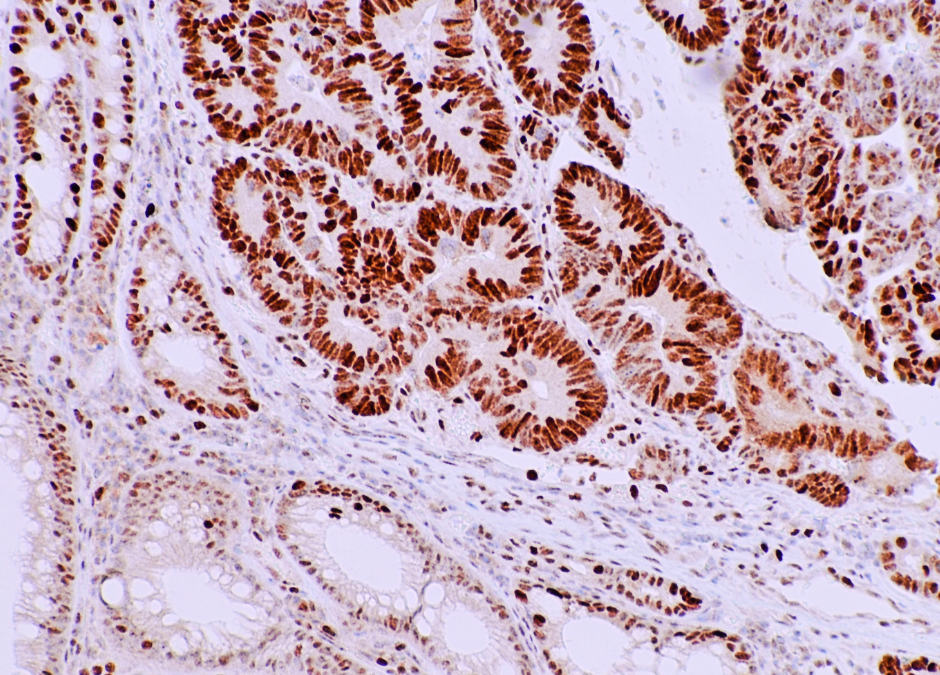

Fasting and Fasting Mimicking: Science Behind Treatment of Metabolic Syndrome, Inflammation and Immune Disorders
March 9, 2022
Stress Management in Physicians
March 29, 2022March Health Awareness Featured Topic: 2022 Update on Colorectal Cancer Screening and Surveillance Recommendations
What is the problem?
While colorectal cancer (CRC) is preventable, it remains a major U.S. public health issue, as it is the third most prevalent and deadly malignancy. New screening guidelines recommend that all Americans at average risk for CRC undergo screening starting at age 45, lowered from age 50. It is estimated that one-third of Americans are not up-to-date with screening. As of 2019, only 67% of eligible individuals had been tested. The U.S. Multi-Society Task Force on CRC released updated recommendations in 2020 on surveillance intervals after colonoscopy and polypectomy. It is imperative to make substantive progress in CRC screening because lives are at stake if we cannot enhance testing uptake.
Learning Objectives
- Identify when patients at average risk for CRC are eligible for screening
- Recognize the recommended tiers of CRC screening testing options and how often they should be performed
- Describe the updated recommended surveillance intervals after colonoscopy and polypectomy
How do we know this is a problem?
https://www.cdc.gov/cancer/colorectal/statistics/index.htm
https://www.uspreventiveservicestaskforce.org/uspstf/recommendation/colorectal-cancer-screening